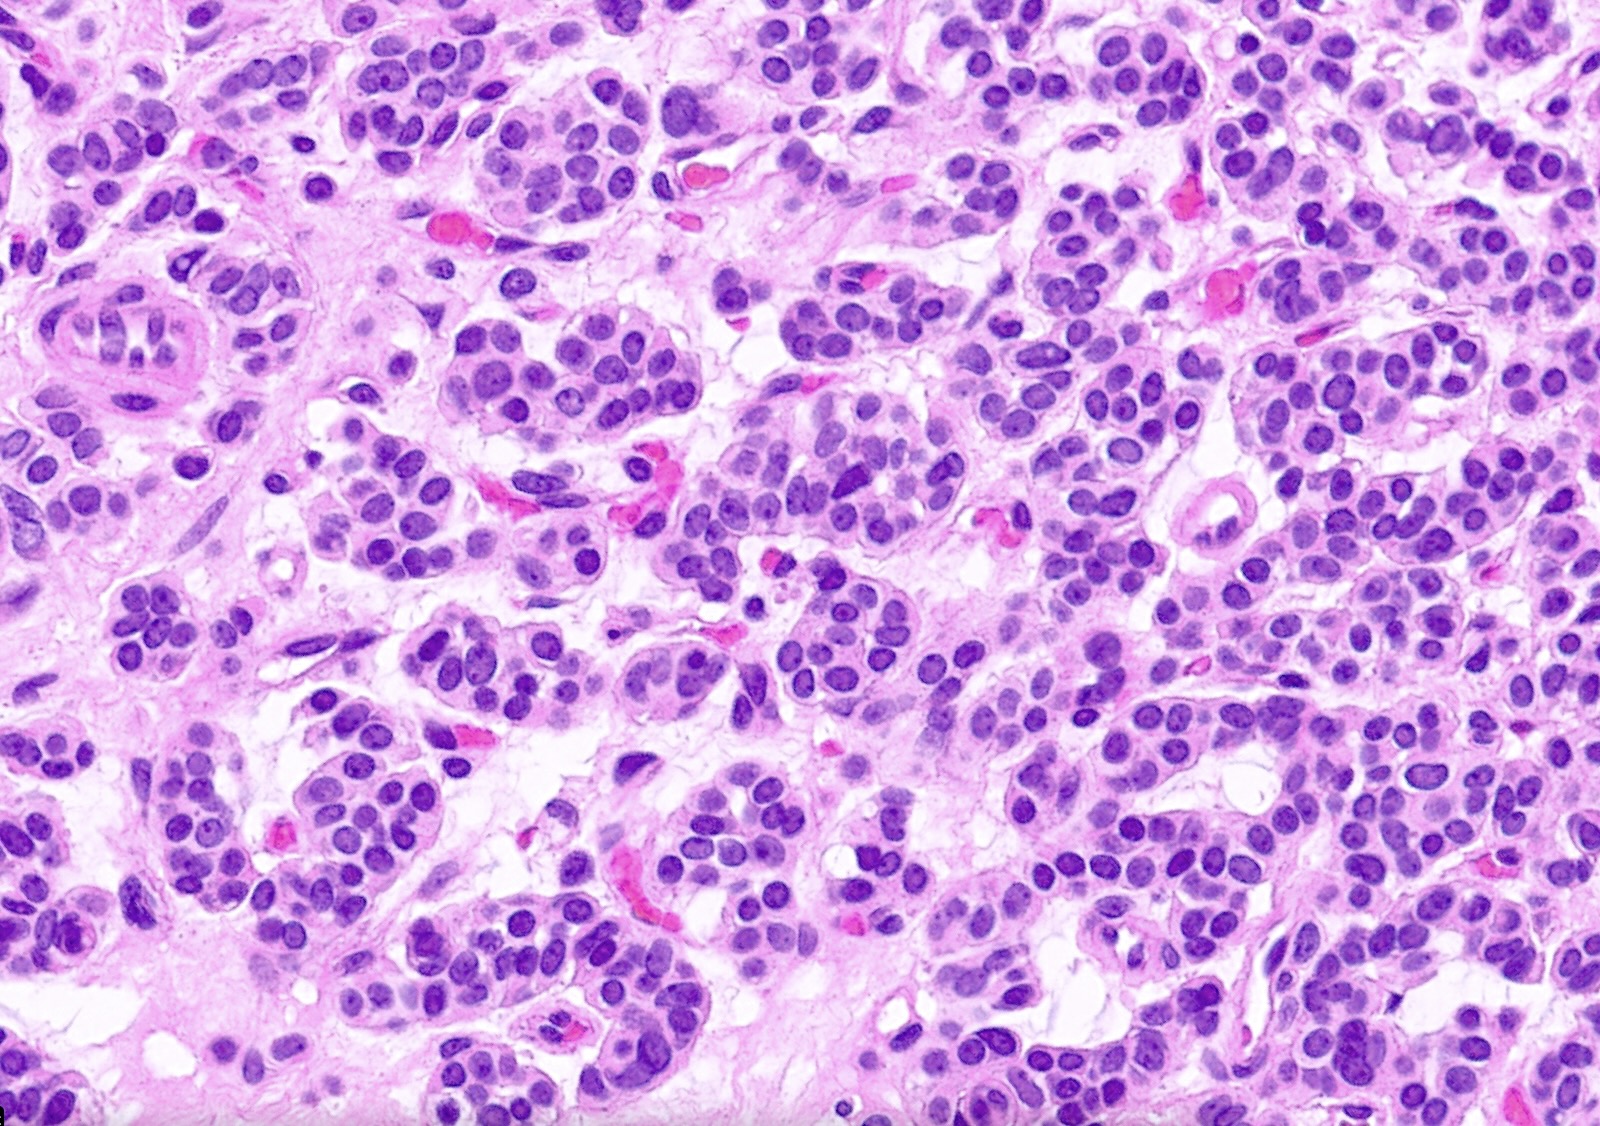
Porn Picture

Welcome to XVirgin - Porn Images Blog
XVirgin is a fresh and user-friendly porn blog and porn search engine.Select a category at the top of the page or enter your porn keywords in the search field above.
We promise you will find everything you desire!
Random images viewed by our users
Random searches by our users
- Hija Con Pap
- Joysporn Xozilla Uncensored ลากเด็กมารุมโทรมเย็ดในป่าคาชุดมอ6กลางวันแสกๆหีโหนกนูนหีอูมๆหีอวมๆ Pussyspace
- Xxx 1 Pornseed
- สาวอวบหุ่นหมีโชว์ของดีอีกแล้วไปตามผลงานเธอได้ที่ Vxxx
- Uncensored พาหลานสาวเข้าไปเย็ดในป่าหลังบ้านหลอกบอกจะพาไปซื้อมือถือหลังเย็ดเสร็จ 4tube Video
- Emmerich Char 3d Updated » Хентая Images Eporner
- คลิปหลุดสาวใหญ่จังหวัดอุบลแหกหีโชว์คาผ้าถุงเลยได้มาจากกลุ่มลับ Galaxyporn Uncensored Megatube
- พาหลานสาวเข้าไปเย็ดในป่าหลังบ้านหลอกบอกจะพาไปซื้อมือถือหลังเย็ดเสร็จ Reddit Secretstash Public Videos
- Porngo น้องกล้วยแขกไลฟ์สดช่วยตัวเองหน้ากล้อง Com Xozilla
- Video Uncensored Bellesa หนังโป๊ไทยพ่อกับลูก พ่อจ๋าทำไมน้ำหล่อลื่นมันเสียวขนาดนี้ Free
- Pussyspace エロ女子大生が絶品おっぱい揺れる本気でいきまくる!!巨チンに感じる清純ムッツリちゃんに大量射精不可避 Tubeorigin
- مع Xhamster2 Reddit Porn
- Viral Video エロ女子大生が絶品おっぱい揺れる本気でいきまくる!!巨チンに感じる清純ムッツリちゃんに大量射精不可避 Mms
- Interracial Www.nbrplaza.com
- Viral Nudes Pmv Onlyfans Leaked Videos Videos
- Skylarskywalker Images Deepfake
- Cumshot Pornerxx.com
- Xhamster Yourdailypornvideos Taxi69 Megatube
- Leaked Video Com Netfapx ลากเด็กมารุมโทรมเย็ดในป่าคาชุดมอ6กลางวันแสกๆหีโหนกนูนหีอูมๆหีอวมๆ Titfap
- Fetish En.laboratuvarstudio.com
- Netfapx Net วิ่งไปแก้ผ้าไปนมเด้งดึ๋งๆใหญ่มาก Netfapx Palimas
- Secretstash Farting While
- Whoreshub Posts ใส่กางเกงในสีขาวเต้นยั่วเอามือล้วงจุดลับ
- Yespornvip Public Videos Net Net Download Drtuber
- Leak นักศึกษาวัยกำลังร่านหีเงี่ยนจัดไม่มีควยเย็ด Mms
- エロ女子大生が絶品おっぱい揺れる本気でいきまくる!!巨チンに感じる清純ムッツリちゃんに大量射精不可避 Tubeorigin Eroticmv
- Redtube Thothub فيلم ښتو پاکستاني
- Vintage Www.indexxx.com
- Com 偷窥美容院,夜幕降临关起门,工作太累了,脱光衣服躺好叫小儿子过来帮忙推油滚背,经儿子这么一推,疲劳全消了,清晰对白哦~ Fakings Secretstash Nudes
- Video Onlyfans Onlyfans Posts Hardcore Images
- Vids Analdin พาหลานสาวเข้าไปเย็ดในป่าหลังบ้านหลอกบอกจะพาไปซื้อมือถือหลังเย็ดเสร็จ Posts
- Grandma Riotheatre.ca
- 偷窥美容院,夜幕降临关起门,工作太累了,妈妈脱光衣服躺好叫小儿子过来帮忙推油滚背,经儿子这么一推,疲劳全消了,清晰对白哦 Leaked
- Bellesa Taxi69 ယွန်းယွန်းနှင့်အောင်မင်းခန့်hd Netfapx Net
- Fapmeifyoucan Download Net Net Cumshot Pornxp Hardcore Images
- Bukkake Lukesteingruby.com
- Beeg น้องนามินมใหญ่ครวบควยไม่เก่งแต่ติ้วหีมัน Cliphunter
- Posts Scandal พาหลานสาวเข้าไปเย็ดในป่าหลังบ้านหลอกบอกจะพาไปซื้อมือถือหลังเย็ดเสร็จ Definebabe Trendyporn
- Hardcore Videos Siska Porndune Net Url Url Net Porno
- Xhamster2 Fakings エロ女子大生が絶品おっぱい揺れる本気でいきまくる!!巨チンに感じる清純ムッツリちゃんに大量射精不可避
- Hardcore น้องนามินมใหญ่ครวบควยไม่เก่งแต่ติ้วหีมัน Fux Com
- Deepfake Paradisehill แอบลักหลับเย็ดหีป้าตัวเองตอนนอนข้างๆกันหยิบเอาควยออกมาแล้วค่อยๆ Recent Video
- エロ女子大生が絶品おっぱい揺れる本気でいきまくる!!巨チンに感じる清純ムッツリちゃんに大量射精不可避 Netfapx Fullporner
- Meckella Images
- Uncensored Tubeorigin พาหลานสาวเข้าไปเย็ดในป่าหลังบ้านหลอกบอกจะพาไปซื้อมือถือหลังเย็ดเสร็จ Animated Full Length Videos
- Beeg 2eritrean 2xtapes Deepfake
- Posts พาหลานสาวเข้าไปเย็ดในป่าหลังบ้านหลอกบอกจะพาไปซื้อมือถือหลังเย็ดเสร็จ Freeomovie Leaks
- Clip แหย่นิ้วเบ็ดหีเพลินๆมีเสียงครางประกอบความ Cliphunter
- Xxx Scenes Netfapx Net น้องขัดขืนก็ไม่สนเอาควยยัดหีให้เงียบ
- Xxx 《番外編》レべチ過ぎ!超~キレカワ激マブ美女!!華奢なのに出るとこ出たスペシャル美ボディー女神! Uncensored Video
Random domains
-
Healingrainbook.com
-
Mandragoria.fr
-
Tr.xhamster1.desi
-
Xiaolv.co
-
Josporn.com
-
Xhamster19.com
-
Riotheatre.ca
-
Www.nbrplaza.com
-
Girls.c64.org
-
Extravafrench.com
-
Apps.urban.org
-
Th.lovepik.com
-
Www.beyazperde.com
-
Wankgod.com
-
Www.tizam.video
-
Www.stfx.ca
-
Www.pornhub.com
-
Aurobindoru.auromaa.org
-
M.drtuber.com
-
Xhtotal.com
-
Xhspot.com
-
Lukesteingruby.com
-
Www.dutis.sk
-
Aqmada.be
-
Huarenav.com
-
Xhaccess.com
-
Www.pathologyoutlines.com
-
Mapsgroup.co.il
-
Ara.xhamster.com
-
Popub.nl
-
Stackdiary.com
-
Www.erome.com
-
Caner104.rssing.com
-
Futurefertility.com
-
Www.caremat.org
-
Fagalicious.com
-
Www.cartoonporn.com
-
En.laboratuvarstudio.com
-
Www.ebar.com
-
Www.primecurves.com
-
Fund.nufdiran.org
-
Www.jpophelp.com
-
Hitparade.ch
-
Fakboi.tv
-
Feuerwehr-bischberg.soft112.com
-
Pornerxx.com
-
Www.auntmia.com
-
Www.indexxx.com
-
Queerpig.com
-
Www.pornpics.de



,webp/024/105/177/1280x720.17025799.jpg)
,webp/005/744/337/1280x720.2.jpg)

(mh=bUbMAPYne_ruv7bt)6.jpg)





(mh=Qbg6C5kYhURMV1od)5.jpg)

,webp/025/146/933/1280x720.17260632.jpg)



















(mh=-9yAyCUHSkGnKgAi)0.jpg)
,webp/025/596/754/v2/2560x1440.208.webp)


